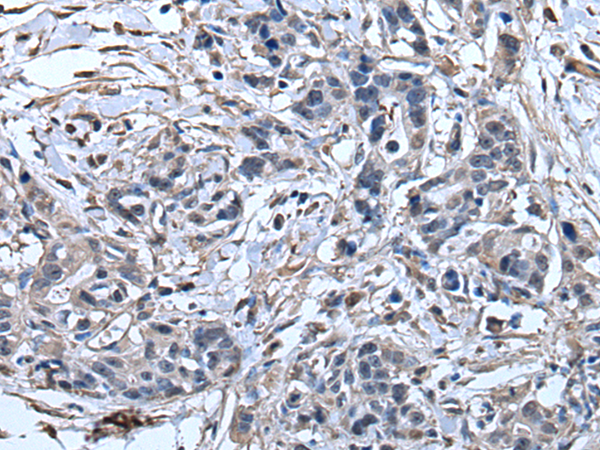

|
Background: |
This gene encodes a secreted inhibitor which protects epithelial tissues from serine proteases. It is found in various secretions including seminal plasma, cervical mucus, and bronchial secretions, and has affinity for trypsin, leukocyte elastase, and cathepsin G. Its inhibitory effect contributes to the immune response by protecting epithelial surfaces from attack by endogenous proteolytic enzymes. This antimicrobial protein has antibacterial, antifungal and antiviral activity. |
|
Applications: |
ELISA, WB, IHC |
|
Name of antibody: |
SLPI |
|
Immunogen: |
Fusion protein of human SLPI |
|
Full name: |
secretory leukocyte peptidase inhibitor |
|
Synonyms: |
ALP; MPI; ALK1; BLPI; HUSI; WAP4; WFDC4; HUSI-I |
|
SwissProt: |
P03973 |
|
ELISA Recommended dilution: |
5000-10000 |
|
IHC positive control: |
Human gastric cancer and human thyroid cancer |
|
IHC Recommend dilution: |
30-150 |
|
WB Predicted band size: |
14 kDa |
|
WB Positive control: |
Human lung tissue lysate |
|
WB Recommended dilution: |
200-1000 |

購物車
幫助
021-54845833/15800441009
